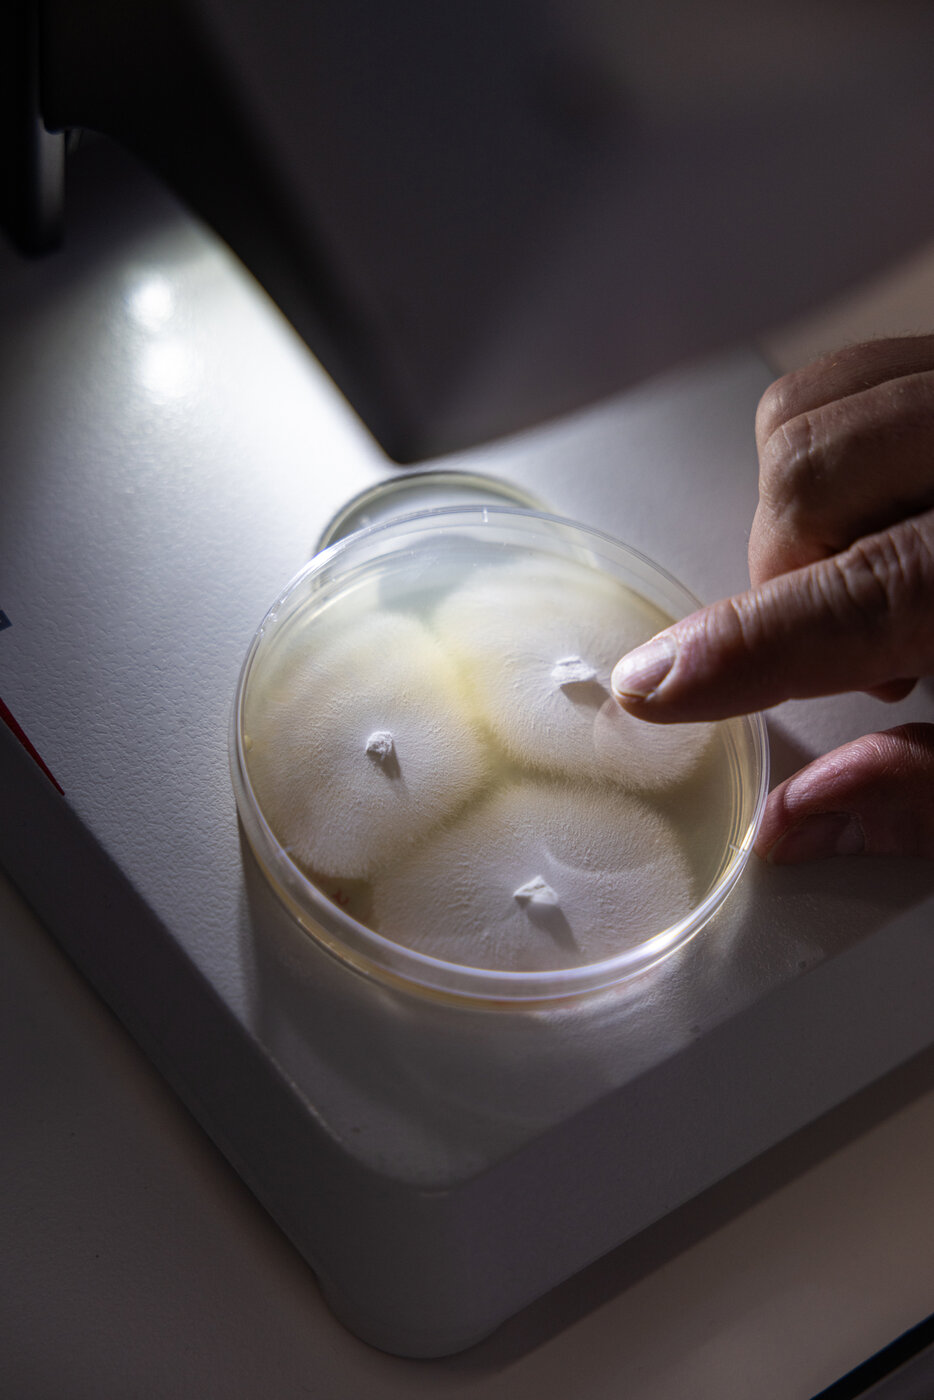

22. März 2023
Getting Started Workshop mit Falko Matthes
Der erste Workshop begann mit einer umfassenden Einführung in die Welt der Mikroorganismen. Dabei wurden grundlegende Fragen zur Klassifizierung von Pflanzen, Pilzen und Bakterien, zu vergangenen Projekten und zu den im BioLab Halle vorkommenden Mikroorganismen behandelt. Anschließend ging der Workshop in die praktische Phase über, in der die Teilnehmenden Laborkittel anzogen und grundlegende Labortechniken erlernten: präzise pH-Messung, genaues Wiegen mit einer Präzisionswaage und die richtige Vorbereitung von Nährmedien. Wir lernten die Bedeutung von Autoklaven, sterilen Arbeitsabläufen, dem Gießen von Agarplatten und der Beimpfung von Pilzkulturen kennen. Der Workshop endete mit einer Demonstration, wie man Wachstum unter dem Mikroskop erkennt und dieses richtig bedient.